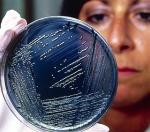

бактерия сальмонелла
Вопросы и ответы по: бактерия сальмонелла
Патогенные представители семейства
Enterobacteriaceae (шигеллы, сальмонеллы) 0 0 0 Не обнаружено
2 Бифидобактерии 10в10 - 10в11 10в9 - 10в11 10в8 - 10в9 Не обнаружено в титре 10в5 и более
3 Лактобактерии 10в6 - 10в7 10в7 - 10в8 10в6 - 10в7 Обнаружено в титре 10в8
5 Энтерококки 10в5 - 10в7 10в5 - 10в8 10в6 - 10в7 Обнаружено в титре 10в7
6 Спорообразующие анаэробы (клостридии) 10в3 10в5 10в6 Не обнаружено в титре 10в3 и более
7 Эшерихии с нормальной ферментативной
активностью
10в7 - 10в8 10в7 - 10в8 10в7 - 10в8 Обнаружено в титре 10в7
8 Лактозонегативные эшерихии 10в5 10в5 10в5 Не обнаружено в титре 10в3 и более
9 Гемолитические эшерихии 0 0 0 Не обнаружено
10 Другие условно-патогенные энтеробактерии 10в4 10в4 10в4 Не обнаружено в титре 10в3 и более
11 S.aureus 0 0 0
Обнаружены Staphylococcus aureus в титре 10в5:
12 Стафилококки (S.epidermidis, S.saprophyticus) 10в4 10в4 10в4 Не обнаружено в титре 10в3 и более
13 Грибы рода Candida 10в3 10в4 10в4 Обнаружено в титре 10в3
14 Неферментирующие бактерии (НГОБ) 10в3 10в4 10в4 Не обнаружено в титре 10в3 и более
помогите пожалуйста, ибо в нашей больнице достойных нет! Надеюсь на Вашу помощь, спасибо заранее!
Bifidobacterium 10^6 10^9 - 10^10
Lactobacillus 10^4 10^6 - 10^7
Clostridium не выделенo <10^5 <10^5
Enterococcus 10^5 10^5 - 10^7
Escherichia coli типичные 10^6 10^7 - 10^8
Escherichia coli лактозонегативные не выделенo <10^5 <10^5
Другие условно-патогенные бактерии 10^5 <10^4
Неферментирующие бактерии не выделенo <10^4
Staphylococcus aureus не выделено <10^2
Staphylococcus saprophiticus не выделено <10^4 - 10^6
Staphylococcus epidermidis не выделено <10^5 - 10^6
Дрожжеподобные грибы рода Candida не выделено <10^4
В индигенной анаэробной части микробиота толстого кишечника снижено количество Bifidobacterium, дефицит Lactobacillus , в индигенной аэробной части снижено количество типичной Escherichia coli на один порядок. Из условно-патогенных энтеробактерий выделен Citrobacter freundii 10^5 КОЕ\г . Патогенной микробиоты не обнаружено.
Антибиотикограмма к Citrobacter freundii
Гентамицин чувствителен
Левомицетин чувствителен
Норфлоксацин чувствителен
Неомицин чувствителен
Цефтибутен чувствителен
Цефиксим чувствителен
Бактериофаг клебсиелл поливалентный очищенный (г. Уфа) устойчив
Бактериофаг коли-протей (г. Н.Новгород) устойчив
Интести-Бактериофаг (г.Пермь) слабочувствителен
ПиоБактериофаг комплексный (г.Н.Новгород) устойчив
Секстафаг (г. Пермь) устойчив
Вздутие живота, с калом выходит крупные куски слизи, дискомфорт в правом подреберье.
Популярные статьи на тему: бактерия сальмонелла

Гуморальный иммунитет является важным компонентом врожденного иммунитета. Давно известно, что нормальная интактная сыворотка крови способна убивать и лизировать многие грамотрицательные бактерии.

Синдром раздраженного кишечника (СРК) – функциональное заболевание, которое встречается у 10-45% населения земного шара. Такой большой разброс цифр обусловлен зачастую качеством диагностики и вообще уровнем медицинской помощи в стране, особенностями...

Нормальная жизнедеятельность человеческого организма предполагает поддержание условий внутренней среды, которые в значительной степени отличаются от условий среды внешней.

Синдром раздраженного кишечника (СРК) в соответствии с рекомендациями Международного совещания экспертов (Римские критерии I, 1988; Римские критерии II, 1999) и Международной классификацией болезней 10-го пересмотра определяется как...

Диарее путешественников в последние годы уделяется большое внимание, значительно возросло число медицинских и просветительских публикаций на эту тему. Это обусловлено увеличивающимся числом путешествующих, миграцией населения, преобладанием этой диареи в.

Шок – собирательное понятие, которым пользуются клиницисты для характеристики особых состояний жизненно важных функций организма.

Дегидратационный шок – патологическое состояние, развивающееся вследствие возникновения катастрофического несоответствия объема циркулирующей крови емкости сосудистого русла из-за нарастающей дегидратации и деминерализации в результате рвоты и диареи.

Острые кишечные инфекции (ОКИ) у детей остаются актуальной проблемой педиатрии ввиду их значительной распространенности, не всегда эффективного применения этиотропных препаратов для их лечения, сопутствующих нарушений качественного и количественного...

В последние годы среди инфекционных болезней, по данным ВОЗ, наиболее распространенными являются бактериальные и вирусные диареи. Проблема острых кишечных инфекций (ОКИ) – одна из актуальнейших и в отечественном здравоохранении.
Новости на тему: бактерия сальмонелла
Бактерии сальмонеллы могут вызывать достаточно тяжелое заболевание под названием сальмонеллез, которое особо опасно для детей и людей с хроническими заболеваниями. Однако итальянские ученые разработали метод, с помощью которого сальмонелла превращается из опасного врага в друга – они открыли, что бактерия может активизировать иммунную систему человека, которая приобретает способность лучше распознавать раковые клетки и успешно уничтожать их. Бактерия также обладает свойством предотвращать процесс метастазирования – распространения злокачественного процесса в организме.

Мучительный понос, вызванный бактериями, часто настигает туристов и командировочных во время пребывания в других странах. Теперь предотвратить «диарею путешественников» можно будет с помощью новой эффективной вакцины, созданной в Англии.

Сальмонеллез – заболевание, столь же распространенное, сколь и опасное. Однако американские ученые обнаружили, что некоторые представители возбудителей этого недуга способны становится во много раз опаснее обычных – в этом случае лекарства бессильны.

Ученые обнаружили в Африке штамм сальмонелл, вызывающих брюшной тиф, который раньше на этом континенте не встречался. Отличительной особенностью нового штамма является его очень высокая устойчивость к действию лекарств.

Во многих семьях вместо привычных собак и кошек теперь в качестве домашних питомцев появились черепахи, ящерицы и даже хамелеоны. Однако содержание рептилий в доме, где есть дети, может грозить маленьким членам семьи тяжелой формой сальмонеллеза.

Американские изобретатели подтвердили правильность изречения о том, что все гениальное просто. Они придумали устройство, которое будет пользоваться спросом у женщин, так как с его помощью можно эффективно уничтожать бактерии на щеточках для туши.

Медики планеты настоятельно рекомендуют хозяйкам последовать ценному совету: куриные тушки и их части ни в коем случае не следует мыть водой в кухонной мойке. От этого может заболеть опасными желудочно-кишечными инфекциями вся семья.

Кроме традиционных любимцев – собак и кошек, люди нередко держат дома совершенно экзотическую живность. Некоторые из таких питомцев могут быть потенциальными источниками опасных бактерий – например, сальмонелл.

В канун Рождества и Нового года резко увеличится продажа кур, индеек и уток, которые станут настоящим украшением праздничного стола. Но американские врачи предупреждают: аппетитная птица вполне может оказаться источником опаснейших микробов.


